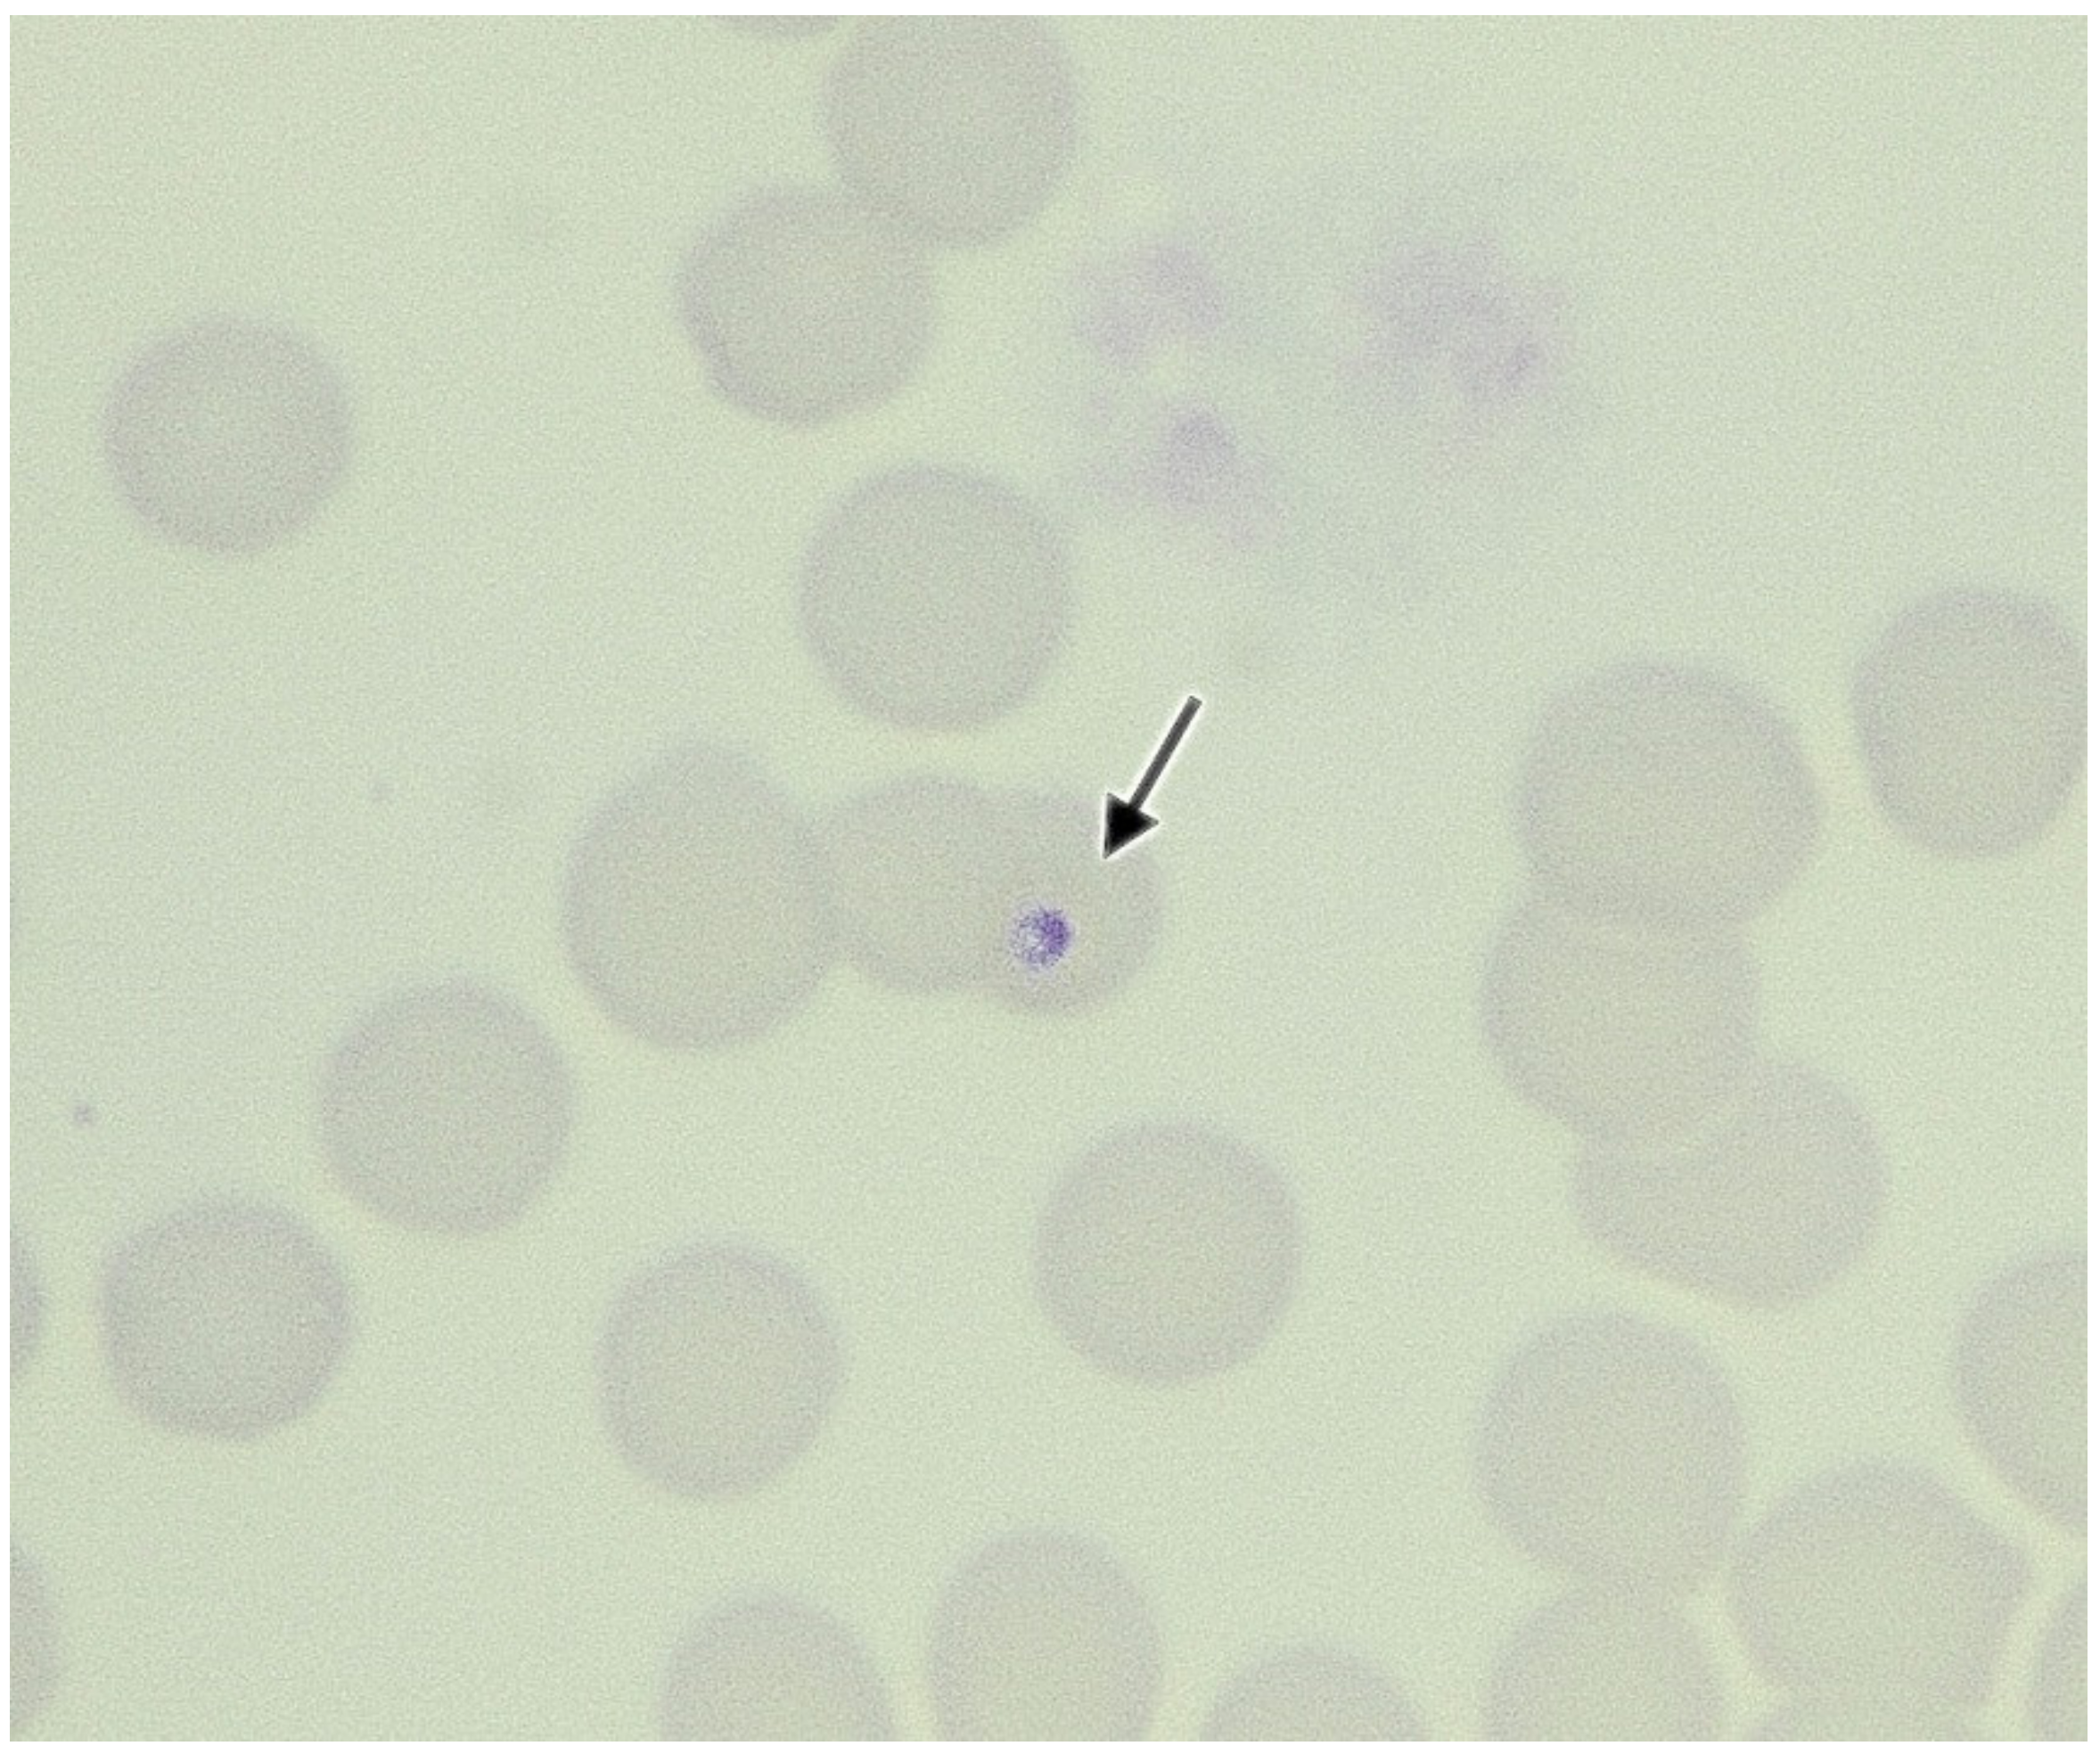
Vetsci 09 00050 g001 Vetsci 09 00050 g001

Cytauxzoon sp. Infection and Coinfections in Three Domestic Cats in Central Italy
Abstract
1. Introduction
2. Case Presentations
3. Biomolecular Analysis
4. Discussion
5. Conclusions
Author Contributions
Funding
Institutional Review Board Statement
Informed Consent Statement
Data Availability Statement
Conflicts of Interest
References
- Meinkoth, J.H.; Kocan, A.A. Feline Cytauxzoonosis. Vet. Clin. N. Am. Small Anim. Pract. 2005, 35, 89–101. [Google Scholar] [CrossRef]
- Brown, H.M.; Lockhart, J.M.; Latimer, K.S.; Peterson, D.S. Identification and Genetic Characterization of Cytauxzoon Felis in Asymptomatic Domestic Cats and Bobcats. Vet. Parasitol. 2010, 172, 311–316. [Google Scholar] [CrossRef]
- Shock, B.C.; Birkenheuer, A.J.; Patton, L.L.; Olfenbuttel, C.; Beringer, J.; Grove, D.M.; Peek, M.; Butfiloski, J.W.; Hughes, D.W.; Lockhart, J.M.; et al. Variation in the ITS-1 and ITS-2 RRNA Genomic Regions of Cytauxzoon Felis from Bobcats and Pumas in the Eastern United States and Comparison with Sequences from Domestic Cats. Vet. Parasitol. 2012, 190, 29–35. [Google Scholar] [CrossRef] [PubMed]
- Glenn, B.L.; Rolley, R.E.; Kocan, A.A. Cytauxzoon-like Piroplasms in Erythrocytes of Wild-Trapped Bobcats in Oklahoma. J. Am. Vet. Med. Assoc. 1982, 181, 1251–1253. [Google Scholar] [PubMed]
- Glenn, B.L.; Kocan, A.A.; Blouin, E.F. Cytauxzoonosis in Bobcats. J. Am. Vet. Med. Assoc. 1983, 183, 1155–1158. [Google Scholar]
- Hoover, J.P.; Walker, D.B.; Hedges, J.D. Cytauxzoonosis in Cats: Eight Cases (1985–1992). J. Am. Vet. Med. Assoc. 1994, 205, 455–460. [Google Scholar] [PubMed]
- Birkenheuer, A.J.; Le, J.A.; Valenzisi, A.M.; Tucker, M.D.; Levy, M.G.; Breitschwerdt, E.B. Cytauxzoon Felis Infection in Cats in the Mid-Atlantic States: 34 Cases (1998–2004). J. Am. Vet. Med. Assoc. 2006, 228, 568–571. [Google Scholar] [CrossRef]
- Hauck, W.N.; Snider, T.G.; Lawrence, J.E. Cytauxzoonosis in a Native Louisiana Cat. J. Am. Vet. Med. Assoc. 1982, 180, 1472–1474. [Google Scholar]
- Meinkoth, J.; Kocan, A.A.; Whitworth, L.; Murphy, G.; Fox, J.C.; Woods, J.P. Cats Surviving Natural Infection with Cytauxzoon Felis: 18 Cases (1997–1998). J. Vet. Intern. Med. 2000, 14, 521–525. [Google Scholar] [CrossRef]
- Meier, H.T.; Moore, L.E. Feline Cytauxzoonosis: A Case Report and Literature Review. J. Am. Anim. Hosp. Assoc. 2000, 36, 493–496. [Google Scholar] [CrossRef]
- Miller, J.; Davis, C.D. Increasing Frequency of Feline Cytauxzoonosis Cases Diagnosed in Western Kentucky from 2001 to 2011. Vet. Parasitol. 2013, 198, 205–208. [Google Scholar] [CrossRef] [PubMed]
- Blouin, E.F.; Kocan, A.A.; Glenn, B.L.; Kocan, K.M.; Hair, J.A. Transmission of Cytauxzoon Felis Kier, 1979 from Bobcats, Felis Rufus (Schreber), to Domestic Cats by Dermacentor Variabilis (Say). J. Wildl. Dis. 1984, 20, 241–242. [Google Scholar] [CrossRef] [PubMed]
- Blouin, E.F.; Kocan, A.A.; Kocan, K.M.; Hair, J. Evidence of a Limited Schizogonous Cycle for Cytauxzoon Felis in Bobcats Following Exposure to Infected Ticks. J. Wildl. Dis. 1987, 23, 499–501. [Google Scholar] [CrossRef]
- Birkenheuer, A.J.; Marr, H.S.; Warren, C.; Acton, A.E.; Mucker, E.M.; Humphreys, J.G.; Tucker, M.D. Cytauxzoon Felis Infections Are Present in Bobcats (Lynx Rufus) in a Region Where Cytauxzoonosis Is Not Recognized in Domestic Cats. Vet. Parasitol. 2008, 153, 126–130. [Google Scholar] [CrossRef] [PubMed]
- Reichard, M.V.; Meinkoth, J.H.; Edwards, A.C.; Snider, T.A.; Kocan, K.M.; Blouin, E.F.; Little, S.E. Transmission of Cytauxzoon Felis to a Domestic Cat by Amblyomma Americanum. Vet. Parasitol. 2009, 161, 110–115. [Google Scholar] [CrossRef]
- Reichard, M.V.; Edwards, A.C.; Meinkoth, J.H.; Snider, T.A.; Meinkoth, K.R.; Heinz, R.E.; Little, S.E. Confirmation of Amblyomma Americanum (Acari: Ixodidae) as a Vector for Cytauxzoon Felis (Piroplasmorida: Theileriidae) to Domestic Cats. J. Med. Entomol. 2010, 47, 890–896. [Google Scholar] [CrossRef]
- Allen, K.E.; Thomas, J.E.; Wohltjen, M.L.; Reichard, M.V. Transmission of Cytauxzoon Felis to Domestic Cats by Amblyomma Americanum Nymphs. Parasites Vectors 2019, 12, 28. [Google Scholar] [CrossRef]
- Thomas, J.E.; Ohmes, C.M.; Payton, M.E.; Hostetler, J.A.; Reichard, M.V. Minimum Transmission Time of Cytauxzoon Felis by Amblyomma Americanum to Domestic Cats in Relation to Duration of Infestation, and Investigation of Ingestion of Infected Ticks as a Potential Route of Transmission. J. Feline Med. Surg. 2018, 20, 67–72. [Google Scholar] [CrossRef]
- Little, S.E.; Barrett, A.W.; Nagamori, Y.; Herrin, B.H.; Normile, D.; Heaney, K.; Armstrong, R. Ticks from Cats in the United States: Patterns of Infestation and Infection with Pathogens. Vet. Parasitol. 2018, 257, 15–20. [Google Scholar] [CrossRef]
- Shock, B.C.; Lockhart, J.M.; Birkenheuer, A.J.; Yabsley, M.J. Detection of a Babesia Species in a Bobcat from Georgia. Sena 2013, 12, 243–247. [Google Scholar] [CrossRef]
- Zieman, E.A.; Jiménez, F.A.; Nielsen, C.K. Concurrent Examination of Bobcats and Ticks Reveals High Prevalence of Cytauxzoon Felis in Southern Illinois. J. Parasitol. 2017, 103, 343–348. [Google Scholar] [CrossRef] [PubMed]
- Yabsley, M.J.; Murphy, S.M.; Cunningham, M.W. Molecular Detection and Characterization of Cytauxzoon Felis and a Babesia Species in Cougars from Florida. J. Wildl. Dis. 2006, 42, 366–374. [Google Scholar] [CrossRef]
- Harvey, J.W.; Dunbar, M.R.; Norton, T.M.; Yabsley, M.J. Laboratory Findings in Acute Cytauxzoon Felis Infection in Cougars (Puma Concolor Couguar) in Florida. J. Zoo Wildl. Med. 2007, 38, 285–291. [Google Scholar] [CrossRef]
- Rotstein, D.S.; Taylor, S.K.; Harvey, J.W.; Bean, J. Hematologic Effects of Cytauxzoonosis in Florida Panthers and Texas Cougars in Florida. J. Wildl. Dis. 1999, 35, 613–617. [Google Scholar] [CrossRef]
- André, M.R.; Adania, C.H.; Machado, R.Z.; Allegretti, S.M.; Felippe, P.A.N.; Silva, K.F.; Nakaghi, A.C.H.; Dagnone, A.S. Molecular Detection of Cytauxzoon Spp. in Asymptomatic Brazilian Wild Captive Felids. J. Wildl. Dis. 2009, 45, 234–237. [Google Scholar] [CrossRef]
- Filoni, C.; Catão-Dias, J.L.; Cattori, V.; Willi, B.; Meli, M.L.; Corrêa, S.H.R.; Marques, M.C.; Adania, C.H.; Silva, J.C.R.; Marvulo, M.F.V.; et al. Surveillance Using Serological and Molecular Methods for the Detection of Infectious Agents in Captive Brazilian Neotropic and Exotic Felids. J. Vet. Diagn. Investig. 2012, 24, 166–173. [Google Scholar] [CrossRef]
- Peixoto, P.V.; Soares, C.O.; Scofield, A.; Santiago, C.D.; França, T.N.; Barros, S.S. Fatal Cytauxzoonosis in Captive-Reared Lions in Brazil. Vet. Parasitol. 2007, 145, 383–387. [Google Scholar] [CrossRef] [PubMed]
- Zinkl, J.G.; McDonald, S.E.; Kier, A.B.; Cippa, S.J.; Small, P.J. Cytauxzoon-like Organisms in Erythrocytes of Two Cheetahs. J. Am. Vet. Med. Assoc. 1981, 179, 1261–1262. [Google Scholar]
- Furtado, M.M.; Taniwaki, S.A.; Metzger, B.; Dos Santos Paduan, K.; O’Dwyer, H.L.; de Almeida Jácomo, A.T.; Porfírio, G.E.O.; Silveira, L.; Sollmann, R.; Tôrres, N.M.; et al. Is the Free-Ranging Jaguar (Panthera Onca) a Reservoir for Cytauxzoon Felis in Brazil? Ticks Tick Borne Dis. 2017, 8, 470–476. [Google Scholar] [CrossRef]
- Zou, F.-C.; Li, Z.; Yang, J.-F.; Chang, J.-Y.; Liu, G.-H.; Lv, Y.; Zhu, X.-Q. Cytauxzoon Felis Infection in Domestic Cats, Yunnan Province, China, 2016. Emerg. Infect. Dis. 2019, 25, 353–354. [Google Scholar] [CrossRef] [PubMed]
- Ceylan, O.; Xuan, X.; Sevinc, F. Primary Tick-Borne Protozoan and Rickettsial Infections of Animals in Turkey. Pathogens 2021, 10, 231. [Google Scholar] [CrossRef] [PubMed]
- Karaca, M.; Akkan, H.A.; Tutuncu, M.; Özdal, N.; Değer, S.; Ağaoğlu, Z. Cytauxzoonosis in Van Cats. YYÜ VET FAK DERG 2007, 18, 37–39. [Google Scholar]
- Soares, C.O. Cytauxzoonose felina é diagnosticada e isolada pela primeira vez na América Latina. Revista Clín. Vet. 2001, 32, 56–58. [Google Scholar]
- Zaeem, M.; Razmi, G.; Khoshnegah, J. The First Detection of Cytauxzoon Felis in a Wild Cat (Felis Silvestris) in Iran. Comp. Clin. Pathol. 2014, 24, 181–184. [Google Scholar] [CrossRef]
- García-Bocanegra, I.; Dubey, J.P.; Martínez, F.; Vargas, A.; Cabezón, O.; Zorrilla, I.; Arenas, A.; Almería, S. Factors Affecting Seroprevalence of Toxoplasma Gondii in the Endangered Iberian Lynx (Lynx Pardinus). Vet. Parasitol. 2010, 167, 36–42. [Google Scholar] [CrossRef]
- Meli, M.L.; Cattori, V.; Martínez, F.; López, G.; Vargas, A.; Simón, M.A.; Zorrilla, I.; Muñoz, A.; Palomares, F.; López-Bao, J.V.; et al. Feline Leukemia Virus and Other Pathogens as Important Threats to the Survival of the Critically Endangered Iberian Lynx (Lynx Pardinus). PLoS ONE 2009, 4, e4744. [Google Scholar] [CrossRef] [PubMed]
- Alvarado-Rybak, M.; Solano-Gallego, L.; Millán, J. A Review of Piroplasmid Infections in Wild Carnivores Worldwide: Importance for Domestic Animal Health and Wildlife Conservation. Parasites Vectors 2016, 9, 538. [Google Scholar] [CrossRef] [PubMed]
- Panait, L.C.; Mihalca, A.D.; Modrý, D.; Juránková, J.; Ionică, A.M.; Deak, G.; Gherman, C.M.; Heddergott, M.; Hodžić, A.; Veronesi, F.; et al. Three New Species of Cytauxzoon in European Wild Felids. Vet. Parasitol. 2021, 290, 109344. [Google Scholar] [CrossRef]
- Ketz-Riley, C.J.; Reichard, M.V.; Van den Bussche, R.A.; Hoover, J.P.; Meinkoth, J.; Kocan, A.A. An Intraerythrocytic Small Piroplasm in Wild-Caught Pallas’s Cats (Otocolobus Manul) from Mongolia. J. Wildl. Dis. 2003, 39, 424–430. [Google Scholar] [CrossRef]
- Reichard, M.V.; Van Den Bussche, R.A.; Meinkoth, J.H.; Hoover, J.P.; Kocan, A.A. A New Species of Cytauxzoon from Pallas’ Cats Caught in Mongolia and Comments on the Systematics and Taxonomy of Piroplasmids. J. Parasitol. 2005, 91, 420–426. [Google Scholar] [CrossRef]
- Malangmei, L.; Ajith Kumar, K.G.; Nandini, A.; Bora, C.A.F.; Varghese, A.; Amrutha, B.M.; Kurbet, P.S.; Pradeep, R.K.; Nimisha, M.; Deepa, C.K.; et al. Molecular Characterization of Hemoparasites and Hemoplasmas Infecting Domestic Cats of Southern India. Front. Vet. Sci. 2020, 7, 597598. [Google Scholar] [CrossRef]
- Rassouli, M.; Sabouri, S.; Goudarzi, A.; Parsa, M. Cytauxzoon Felis in a Stray Cat in Iran. Comp. Clin. Pathol. 2015, 1, 75–77. [Google Scholar] [CrossRef]
- Leclaire, S.; Menard, S.; Berry, A. Molecular Characterization of Babesia and Cytauxzoon Species in Wild South-African Meerkats. Parasitology 2015, 142, 543–548. [Google Scholar] [CrossRef] [PubMed]
- Jinnai, M.; Kawabuchi-Kurata, T.; Tsuji, M.; Nakajima, R.; Hirata, H.; Fujisawa, K.; Shiraki, H.; Asakawa, M.; Nasuno, T.; Ishihara, C. Molecular Evidence of the Multiple Genotype Infection of a Wild Hokkaido Brown Bear (Ursus Arctos Yesoensis) by Babesia Sp. UR1. Vet. Parasitol. 2010, 173, 128–133. [Google Scholar] [CrossRef]
- Ortuño, M.; Nachum-Biala, Y.; García-Bocanegra, I.; Resa, M.; Berriatua, E.; Baneth, G. An Epidemiological Study in Wild Carnivores from Spanish Mediterranean Ecosystems Reveals Association between Leishmania Infantum, Babesia Spp. and Hepatozoon Spp. Infection and New Hosts for Hepatozoon Martis, Hepatozoon Canis and Sarcocystis spp. Transbound. Emerg. Dis. 2021. [Google Scholar] [CrossRef] [PubMed]
- Panait, L.C.; Stock, G.; Globokar, M.; Balzer, J.; Groth, B.; Mihalca, A.D.; Pantchev, N. First Report of Cytauxzoon Sp. Infection in Germany: Organism Description and Molecular Confirmation in a Domestic Cat. Parasitol. Res. 2020, 119, 3005–3011. [Google Scholar] [CrossRef] [PubMed]
- Veronesi, F.; Ravagnan, S.; Cerquetella, M.; Carli, E.; Olivieri, E.; Santoro, A.; Pesaro, S.; Berardi, S.; Rossi, G.; Ragni, B.; et al. First Detection of Cytauxzoon Spp. Infection in European Wildcats (Felis Silvestris Silvestris) of Italy. Ticks Tick Borne Dis. 2016, 7, 853–858. [Google Scholar] [CrossRef] [PubMed]
- Alho, A.M.; Silva, J.; Fonseca, M.J.; Santos, F.; Nunes, C.; de Carvalho, L.M.; Rodrigues, M.; Cardoso, L. First Report of Cytauxzoon Sp. Infection in a Domestic Cat from Portugal. Parasites Vectors 2016, 9, 220. [Google Scholar] [CrossRef]
- Carli, E.; Trotta, M.; Bianchi, E.; Furlanello, T.; Caldin, M.; Pietrobelli, M.; Solano-Gallego, L. Cytauxzoon Sp. Infection in Two Free Ranging Young Cats: Clinicopathological Findings, Therapy and Follow Up. Turkiye Parazitol. Derg. 2014, 38, 185–189. [Google Scholar] [CrossRef] [PubMed]
- Legroux, J.-P.; Halos, L.; René-Martellet, M.; Servonnet, M.; Pingret, J.-L.; Bourdoiseau, G.; Baneth, G.; Chabanne, L. First Clinical Case Report of Cytauxzoon Sp. Infection in a Domestic Cat in France. BMC Vet. Res. 2017, 13, 81. [Google Scholar] [CrossRef]
- Nentwig, A.; Meli, M.L.; Schrack, J.; Reichler, I.M.; Riond, B.; Gloor, C.; Howard, J.; Hofmann-Lehmann, R.; Willi, B. First Report of Cytauxzoon Sp. Infection in Domestic Cats in Switzerland: Natural and Transfusion-Transmitted Infections. Parasites Vectors 2018, 11, 292. [Google Scholar] [CrossRef] [PubMed]
- Gallusová, M.; Jirsová, D.; Mihalca, A.D.; Gherman, C.M.; D’Amico, G.; Qablan, M.A.; Modrý, D. Cytauxzoon Infections in Wild Felids from Carpathian-Danubian-Pontic Space: Further Evidence for a Different Cytauxzoon Species in European Felids. J. Parasitol. 2016, 102, 377–380. [Google Scholar] [CrossRef] [PubMed]
- Mylonakis, M.E.; Schreeg, M.; Chatzis, M.K.; Pearce, J.; Marr, H.S.; Saridomichelakis, M.N.; Birkenheuer, A.J. Molecular Detection of Vector-Borne Pathogens in Greek Cats. Ticks Tick Borne Dis. 2018, 9, 171–175. [Google Scholar] [CrossRef] [PubMed]
- Criado-Fornelio, A.; Buling, A.; Pingret, J.L.; Etievant, M.; Boucraut-Baralon, C.; Alongi, A.; Agnone, A.; Torina, A. Hemoprotozoa of Domestic Animals in France: Prevalence and Molecular Characterization. Vet. Parasitol. 2009, 159, 73–76. [Google Scholar] [CrossRef]
- Carli, E.; Trotta, M.; Chinelli, R.; Drigo, M.; Sinigoi, L.; Tosolini, P.; Furlanello, T.; Millotti, A.; Caldin, M.; Solano-Gallego, L. Cytauxzoon Sp. Infection in the First Endemic Focus Described in Domestic Cats in Europe. Vet. Parasitol. 2012, 183, 343–352. [Google Scholar] [CrossRef] [PubMed]
- Díaz-Regañón, D.; Villaescusa, A.; Ayllón, T.; Rodríguez-Franco, F.; Baneth, G.; Calleja-Bueno, L.; García-Sancho, M.; Agulla, B.; Sainz, Á. Molecular Detection of Hepatozoon Spp. and Cytauxzoon Sp. in Domestic and Stray Cats from Madrid, Spain. Parasites Vectors 2017, 10, 112. [Google Scholar] [CrossRef]
- Morganti, G.; Veronesi, F.; Stefanetti, V.; Di Muccio, T.; Fiorentino, E.; Diaferia, M.; Santoro, A.; Passamonti, F.; Gramiccia, M. Emerging Feline Vector-Borne Pathogens in Italy. Parasites Vectors 2019, 12, 193. [Google Scholar] [CrossRef]
- Ebani, V.V.; Guardone, L.; Marra, F.; Altomonte, I.; Nardoni, S.; Mancianti, F. Arthropod-Borne Pathogens in Stray Cats from Northern Italy: A Serological and Molecular Survey. Animals 2020, 10, 2334. [Google Scholar] [CrossRef]
- Spada, E.; Proverbio, D.; Galluzzo, P.; Perego, R.; Bagnagatti De Giorgi, G.; Roggero, N.; Caracappa, S. Frequency of Piroplasms Babesia Microti and Cytauxzoon Felis in Stray Cats from Northern Italy. Biomed Res. Int. 2014, 2014, 943754. [Google Scholar] [CrossRef]
- Persichetti, M.F.; Pennisi, M.G.; Vullo, A.; Masucci, M.; Migliazzo, A.; Solano-Gallego, L. Clinical Evaluation of Outdoor Cats Exposed to Ectoparasites and Associated Risk for Vector-Borne Infections in Southern Italy. Parasites Vectors 2018, 11, 136. [Google Scholar] [CrossRef]
- Grillini, M.; Simonato, G.; Tessarin, C.; Dotto, G.; Traversa, D.; Cassini, R.; Marchiori, E.; Frangipane di Regalbono, A. Cytauxzoon Sp. and Hepatozoon Spp. in Domestic Cats: A Preliminary Study in North-Eastern Italy. Pathogens 2021, 10, 1214. [Google Scholar] [CrossRef]
- Solano-Gallego, L. Best known and less known hemoprotozoa of pets. In Proceedings of the XXXI Congress SoIPa & ESDA EVENT, Teramo, Italy, 16–19 June 2021; p. 41. [Google Scholar]
- Wang, J.-L.; Li, T.-T.; Liu, G.-H.; Zhu, X.-Q.; Yao, C. Two Tales of Cytauxzoon Felis Infections in Domestic Cats. Clin. Microbiol. Rev. 2017, 30, 861–885. [Google Scholar] [CrossRef] [PubMed]
- Clarke, L.L.; Krimer, P.M.; Rissi, D.R. Glial Changes and Evidence for Apoptosis in the Brain of Cats Infected by Cytauxzoon Felis. J. Comp. Pathol. 2017, 156, 147–151. [Google Scholar] [CrossRef]
- Haber, M.D.; Tucker, M.D.; Marr, H.S.; Levy, J.K.; Burgess, J.; Lappin, M.R.; Birkenheuer, A.J. The Detection of Cytauxzoon Felis in Apparently Healthy Free-Roaming Cats in the USA. Vet. Parasitol. 2007, 146, 316–320. [Google Scholar] [CrossRef]
- Brown, H.M.; Latimer, K.S.; Erikson, L.E.; Cashwell, M.E.; Britt, J.O.; Peterson, D.S. Detection of Persistent Cytauxzoon Felis Infection by Polymerase Chain Reaction in Three Asymptomatic Domestic Cats. J. Vet. Diagn. Investig. 2008, 20, 485–488. [Google Scholar] [CrossRef] [PubMed]
- Lewis, K.M.; Cohn, L.A.; Downey, M.E.; Whitney, M.S.; Birkenheuer, A.J. Evaluation of Cytauxzoon Felis Infection Status in Captive-Born Wild Felids Housed in an Area Endemic for the Pathogen. J. Am. Vet. Med. Assoc. 2012, 241, 1088–1092. [Google Scholar] [CrossRef] [PubMed]
- Wikander, Y.M.; Kang, Q.; Reif, K.E. Acute Cytauxzoon Felis Cases in Domestic Cats from Eastern Kansas, a Retrospective Case-Control Study (2006–2019). Vet. Sci. 2020, 7, 205. [Google Scholar] [CrossRef]
- Rizzi, T.E.; Reichard, M.V.; Cohn, L.A.; Birkenheuer, A.J.; Taylor, J.D.; Meinkoth, J.H. Prevalence of Cytauxzoon Felis Infection in Healthy Cats from Enzootic Areas in Arkansas, Missouri, and Oklahoma. Parasites Vectors 2015, 8, 13. [Google Scholar] [CrossRef]
- Cohn, L.A.; Shaw, D.; Shoemake, C.; Birkenheuer, A.J. Second Illness Due to Subsequent Cytauxzoon Felis Infection in a Domestic Cat. JFMS Open Rep. 2020, 6, 2055116920908963. [Google Scholar] [CrossRef]
- Casati, S.; Sager, H.; Gern, L.; Piffaretti, J.-C. Presence of Potentially Pathogenic Babesia Sp. for Human in Ixodes Ricinus in Switzerland. Ann. Agric. Environ. Med. 2006, 13, 65–70. [Google Scholar]
- Willi, B.; Meli, M.L.; Lüthy, R.; Honegger, H.; Wengi, N.; Hoelzle, L.E.; Reusch, C.E.; Lutz, H.; Hofmann-Lehmann, R. Development and Application of a Universal Hemoplasma Screening Assay Based on the SYBR Green PCR Principle. J. Clin. Microbiol. 2009, 47, 4049–4054. [Google Scholar] [CrossRef] [PubMed]
- Ravagnan, S.; Carli, E.; Piseddu, E.; Da Rold, G.; Porcellato, E.; Zanardello, C.; Carminato, A.; Vascellari, M.; Capelli, G. Prevalence and Molecular Characterization of Canine and Feline Hemotropic Mycoplasmas (Hemoplasmas) in Northern Italy. Parasites Vectors 2017, 10, 132. [Google Scholar] [CrossRef] [PubMed]
- Tamura, K.; Stecher, G.; Peterson, D.; Filipski, A.; Kumar, S. MEGA6: Molecular Evolutionary Genetics Analysis Version 6.0. Mol. Biol. Evol. 2013, 30, 2725–2729. [Google Scholar] [CrossRef] [PubMed]
- Sherrill, M.K.; Cohn, L.A. Cytauxzoonosis: Diagnosis and Treatment of an Emerging Disease. J. Feline Med. Surg. 2015, 17, 940–948. [Google Scholar] [CrossRef]
- Berent, L.M.; Messick, J.B.; Cooper, S.K. Detection of Haemobartonella Felis in Cats with Experimentally Induced Acute and Chronic Infections, Using a Polymerase Chain Reaction Assay. Am. J. Vet. Res. 1998, 59, 1215–1220. [Google Scholar]
- Foley, J.E.; Harrus, S.; Poland, A.; Chomel, B.; Pedersen, N.C. Molecular, Clinical, and Pathologic Comparison of Two Distinct Strains of Haemobartonella Felis in Domestic Cats. Am. J. Vet. Res. 1998, 59, 1581–1588. [Google Scholar]
- Westfall, D.S.; Jensen, W.A.; Reagan, W.J.; Radecki, S.V.; Lappin, M.R. Inoculation of Two Genotypes of Hemobartonella Felis (California and Ohio Variants) to Induce Infection in Cats and the Response to Treatment with Azithromycin. Am. J. Vet. Res. 2001, 62, 687–691. [Google Scholar] [CrossRef]
- Willi, B.; Boretti, F.S.; Cattori, V.; Tasker, S.; Meli, M.L.; Reusch, C.; Lutz, H.; Hofmann-Lehmann, R. Identification, Molecular Characterization, and Experimental Transmission of a New Hemoplasma Isolate from a Cat with Hemolytic Anemia in Switzerland. J. Clin. Microbiol. 2005, 43, 2581–2585. [Google Scholar] [CrossRef]
- Mendes-de-Almeida, F.; Labarthe, N.; Guerrero, J.; Faria, M.C.F.; Branco, A.S.; Pereira, C.D.; Barreira, J.D.; Pereira, M.J.S. Follow-up of the Health Conditions of an Urban Colony of Free-Roaming Cats (Felis Catus Linnaeus, 1758) in the City of Rio de Janeiro, Brazil. Vet. Parasitol. 2007, 147, 9–15. [Google Scholar] [CrossRef]
- André, M.R.; Filgueira, K.D.; Calchi, A.C.; de Sousa, K.C.M.; Gonçalves, L.R.; Medeiros, V.B.; Ximenes, P.A.; Lelis, I.C.N.G.; de Meireles, M.V.N.; Machado, R.Z. Co-Infection with Arthropod-Borne Pathogens in Domestic Cats. Rev. Bras. Parasitol. Vet. 2017, 26, 525–531. [Google Scholar] [CrossRef]
- Maia, L.M.P.; de Mello Figueiredo Cerqueira, A.; de Barros Macieira, D.; de Souza, A.M.; Moreira, N.S.; da Silva, A.V.; Messick, J.B.; Ferreira, R.F.; Almosny, N.R.P. Cytauxzoon Felis and “Candidatus Mycoplasma Haemominutum” Coinfection in a Brazilian Domestic Cat (Felis Catus). Rev. Bras. Parasitol. Vet. 2013, 22, 289–291. [Google Scholar] [CrossRef]
- Latrofa, M.S.; Iatta, R.; Toniolo, F.; Furlanello, T.; Ravagnan, S.; Capelli, G.; Schunack, B.; Chomel, B.; Zatelli, A.; Mendoza-Roldan, J.; et al. A Molecular Survey of Vector-Borne Pathogens and Haemoplasmas in Owned Cats across Italy. Parasites Vectors 2020, 13, 116. [Google Scholar] [CrossRef]
- Gentilini, F.; Novacco, M.; Turba, M.E.; Willi, B.; Bacci, M.L.; Hofmann-Lehmann, R. Use of Combined Conventional and Real-Time PCR to Determine the Epidemiology of Feline Haemoplasma Infections in Northern Italy. J. Feline Med. Surg. 2009, 11, 277–285. [Google Scholar] [CrossRef]
- Cohn, L.A.; Birkenheuer, A.J.; Brunker, J.D.; Ratcliff, E.R.; Craig, A.W. Efficacy of Atovaquone and Azithromycin or Imidocarb Dipropionate in Cats with Acute Cytauxzoonosis. J. Vet. Intern. Med. 2011, 25, 55–60. [Google Scholar] [CrossRef] [PubMed]
- Museux, K.; Boretti, F.S.; Willi, B.; Riond, B.; Hoelzle, K.; Hoelzle, L.E.; Wittenbrink, M.M.; Tasker, S.; Wengi, N.; Reusch, C.E.; et al. In Vivo Transmission Studies of “Candidatus Mycoplasma Turicensis” in the Domestic Cat. Vet. Res. 2009, 40, 45. [Google Scholar] [CrossRef]
- Lewis, K.M.; Cohn, L.A.; Birkenheuer, A.J. Lack of Evidence for Perinatal Transmission of Cytauxzoon Felis in Domestic Cats. Vet. Parasitol. 2012, 188, 172–174. [Google Scholar] [CrossRef]
- Marenzoni, M.L.; Antognoni, M.T.; Baldelli, F.; Miglio, A.; Stefanetti, V.; Desario, C.; Di Summa, A.; Buonavoglia, C.; Decaro, N. Detection of Parvovirus and Herpesvirus DNA in the Blood of Feline and Canine Blood Donors. Vet. Microbiol. 2018, 224, 66–69. [Google Scholar] [CrossRef] [PubMed]
- Tommaso, M.D.; Miglio, A.; Crisi, P.E.; Boari, A.; Rocconi, F.; Antognoni, M.T.; Luciani, A. Frequency of Blood Types A, B and AB in a Population of Non-Pedigree Domestic Cats from Central Italy. Animals 2020, 10, 1937. [Google Scholar] [CrossRef]
- Marenzoni, M.L.; Lauzi, S.; Miglio, A.; Coletti, M.; Arbia, A.; Paltrinieri, S.; Antognoni, M.T. Comparison of Three Blood Transfusion Guidelines Applied to 31 Feline Donors to Minimise the Risk of Transfusion-Transmissible Infections. J. Feline Med. Surg. 2018, 20, 663–673. [Google Scholar] [CrossRef]
- Antognoni, M.T.; Birettoni, F.; Miglio, A.; Lalli, P.; Porciello, F.; Mangili Pecci, V. Monoclonal gammopathy associated with multiple myeloma and visceral leishmaniasis in the dog: A comparison of two cases. Vet. Res. Commun. 2010, 34 (Suppl. 1), 97–101. [Google Scholar] [CrossRef]

| Parameter | Cat n. 1 | Cat n. 2 | Cat n. 3 | Reference Range |
|---|---|---|---|---|
| RBCs (×106/mcL) | 3.79 | 7.76 | 3.02 | 5.0–10.0 |
| Hb (g/dL) | 5.5 | 10.5 | 3.3 | 8.0–15.0 |
| Hct (%) | 17.4 | 31.9 | 10.4 | 24–55 |
| MCV (fL) | 45.9 | 41.1 | 34.4 | 39–55 |
| MCH (pg) | 12.9 | 14.5 | 13.5 | 13–18 |
| MCHC (%) | 31.6 | 32.9 | 31.7 | 30–36 |
| RDW (%) | 20.2 | 20.8 | 22.3 | 19.7–29.3 |
| WBCs (×103/mcL) | 7.550 | 4.660 | 14.930 | 5.5–15.5 |
| Neutrophils (n.) | 4.832 | 2.970 | 2.514 | 2.500–12.800 |
| Lymphocytes (n.) | 1.963 | 1.560 | 12.386 | 1.500–7.000 |
| Monocytes (n.) | 604 | 350 | 0 | 0–850 |
| Eosinophils (n.) | 151 | 80 | 30 | 0–150 |
| Basophils (n.) | 0 | 0 | 0 | 0–100 |
| PLTs (×103/mcL) | 12 | 508 | 49 | 300–800 |
| MPV (fL) | 22 | 17 | 15 | 11–18 |
| AST (IU/L) | 40 | 28 | 143 | 14–40 |
| ALT (IU/L) | 50 | 113 | 18 | 6–40 |
| ALP (IU/L) | 51 | 63 | 8 | 7–30 |
| GGT (IU/L) | 4 | 1 | <10 | |
| Total bilirubin (mg/dL) | 1.99 | 0.06 | 1.01 | 1.15–1.20 |
| Cholesterol (mg/dL) | 172 | 121 | 136 | 75–150 |
| TGs (mg/dL) | 64 | 24 | 53 | 50–100 |
| Urea (mg/dL) | 42 | 42 | 61 | 20–30 |
| CPK (IU/L) | 210 | 350 | 402 | 50–493 |
| LDH (IU/L) | 1480 | 234 | 3165 | 75–490 |
| Creatinine (mg/dL) | 1.09 | 1.18 | 0.71 | 1.0–2.0 |
| Glucose (mg/dL) | 100 | 132 | 51 | 64–120 |
| Calcium (mg/dL) | 8.9 | 10.6 | 7.0 | 7.0–10.0 |
| Phosphorus (mg/dL) | 4.6 | 5.6 | 4.8 | 2.5–5.0 |
| Sodium (mEq/L) | 150 | 152 | 139 | 138–152 |
| Potassium (mEq/L) | 4.2 | 3.8 | 3.8 | 3.4–5.1 |
| Chloride (mEq/L) | 110 | 118 | 115 | 100–120 |
| TP (g/dL) | 8.4 | 7.3 | 6.0 | 6.0–8.5 |
| Albumin (g/dL) | 2.7 | 3.3 | 1.4 | 2.1–3.3 |
| Globulin (g/dL) | 5.7 | 4.0 | 4.6 | 3.0–3.8 |
| Albumin/Globulin | 0.5 | 0.8 | 0.3 | 0.4–1.7 |
| FIV | Positive | Negative | Positive | |
| FeLV | Negative | Negative | Negative |
Publisher’s Note: MDPI stays neutral with regard to jurisdictional claims in published maps and institutional affiliations. |
© 2022 by the authors. Licensee MDPI, Basel, Switzerland. This article is an open access article distributed under the terms and conditions of the Creative Commons Attribution (CC BY) license (https://creativecommons.org/licenses/by/4.0/).
Share and Cite
Antognoni, M.T.; Rocconi, F.; Ravagnan, S.; Vascellari, M.; Capelli, G.; Miglio, A.; Di Tommaso, M. Cytauxzoon sp. Infection and Coinfections in Three Domestic Cats in Central Italy. Vet. Sci. 2022, 9, 50. https://doi.org/10.3390/vetsci9020050
Antognoni MT, Rocconi F, Ravagnan S, Vascellari M, Capelli G, Miglio A, Di Tommaso M. Cytauxzoon sp. Infection and Coinfections in Three Domestic Cats in Central Italy. Veterinary Sciences. 2022; 9(2):50. https://doi.org/10.3390/vetsci9020050
Chicago/Turabian StyleAntognoni, Maria Teresa, Francesca Rocconi, Silvia Ravagnan, Marta Vascellari, Gioia Capelli, Arianna Miglio, and Morena Di Tommaso. 2022. "Cytauxzoon sp. Infection and Coinfections in Three Domestic Cats in Central Italy" Veterinary Sciences 9, no. 2: 50. https://doi.org/10.3390/vetsci9020050
APA StyleAntognoni, M. T., Rocconi, F., Ravagnan, S., Vascellari, M., Capelli, G., Miglio, A., & Di Tommaso, M. (2022). Cytauxzoon sp. Infection and Coinfections in Three Domestic Cats in Central Italy. Veterinary Sciences, 9(2), 50. https://doi.org/10.3390/vetsci9020050

